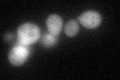
YBR252W
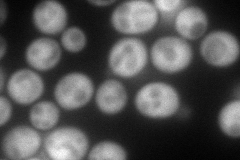
YBR252W
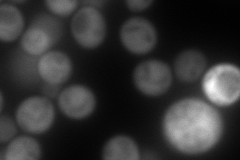
YBR252W
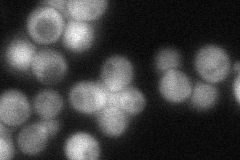
YBR252W
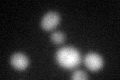
YBR252W
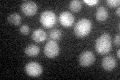
YBR252W

View description
dUTPase, catalyzes hydrolysis of dUTP to dUMP and PPi, thereby preventing incorporation of uracil into DNA during replication; critical for the maintenance of genetic stability
Localization:
Intensity:
Fold change:
Significance:
-
C’ GFP library in SD
cytosol60.08 -
N' NOP1pr-GFP in SD
cytosol192.325 -
N' TEF2pr-mCherry in SD
cytosol235.54 -
N' NATIVEpr-GFP in SD
cytosol67.4832 -
N' TEF2pr-VC and Cyto-VN in SD

#N/A0 -
C’ GFP library in SD+DTT
cytosol39.220.65No -
C’ GFP library in SD+H2O2

cytosol45.290.75No -
C’ GFP library in Starvation Media
cytosol30.470.5No -
C’ GFP library on the background of Pup2-DaMP

cytosol -
C’ GFP library on the background of CCT mutant

cytosol38.08070.633758Yes
